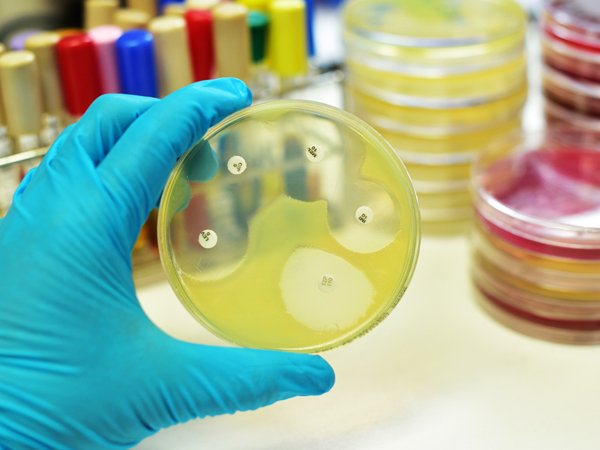

Latest Updates
-
UGC NET ಪರೀಕ್ಷೆ: ಪರೀಕ್ಷೆಯ ಒತ್ತಡದ ನಡುವೆ ಮನೆಯಲ್ಲಿ ನೆಮ್ಮದಿ ಕಾಪಾಡಿಕೊಳ್ಳುವುದು ಹೇಗೆ? -
ದೆಹಲಿ-ಎನ್ಸಿಆರ್ನಲ್ಲಿ ಭಾರಿ ಬಿರುಗಾಳಿ ಎಚ್ಚರಿಕೆ: ನಿಮ್ಮ ಮನೆಯನ್ನು ಸುರಕ್ಷಿತವಾಗಿಡಲು ಈಗಲೇ ಈ ಕೆಲಸ ಮಾಡಿ! -
ಭಾರಿ ಮಳೆ, ವಿದ್ಯುತ್ ಕಡಿತ: ಸಂಕಷ್ಟದ ಸಮಯದಲ್ಲಿ ನಿಮ್ಮ ಆರೋಗ್ಯ ಮತ್ತು ಆಹಾರ ಸುರಕ್ಷತೆ ಕಾಪಾಡಿಕೊಳ್ಳುವುದು ಹೇಗೆ? -
ಮುಂಬೈನಲ್ಲಿ ವರುಣನ ಆರ್ಭಟ: ರೆಡ್ ಅಲರ್ಟ್ ಘೋಷಣೆ, ಪ್ರಯಾಣಿಕರೇ ಎಚ್ಚರ! -
ದೆಹಲಿ-ಎನ್ಸಿಆರ್ನಲ್ಲಿ ಧೂಳಿನ ಆರ್ಭಟ: ಹೊರಗೆ ಹೋಗುವ ಮುನ್ನ ಎಚ್ಚರ, ಮನೆಯಲ್ಲೇ ಫಿಟ್ ಆಗಿರಲು ಈ 8 ನಿಮಿಷದ ಟಿಪ್ಸ್! -
ಟೆಲಿಗ್ರಾಂ ಬಳಕೆದಾರರೇ ಗಮನಿಸಿ: ಸೇವೆ ಆರಂಭವಾದರೂ ಈ ಬದಲಾವಣೆ ಮರೆಯದಿರಿ! -
ಬಿಸಿಗಾಳಿಯ ಎಚ್ಚರಿಕೆ: ಅಡುಗೆ ಮಾಡದೆಯೇ ದೇಹಕ್ಕೆ ತಂಪು ನೀಡುವ ಪ್ರೋಟೀನ್ ಆಹಾರಗಳಿವು! -
ಮಳೆಯ ನಡುವೆ ಯುಜಿಸಿ ನೆಟ್ ಪರೀಕ್ಷೆ: ಸಂಗಾತಿಯ ಈ ಸಣ್ಣ ಬೆಂಬಲವೇ ಯಶಸ್ಸಿನ ಗುಟ್ಟು -
ಮಳೆಗಾಲದಲ್ಲಿ ಮನೆಯ ಪೀಠೋಪಕರಣ ಹಾಳಾಗುತ್ತಿದೆಯೇ? ಬೂಸು ತಡೆಯಲು ಈ ಸರಳ ಟಿಪ್ಸ್ ಪಾಲಿಸಿ -
ಮುಂಬೈ ಆರೆಂಜ್ ಅಲರ್ಟ್: ಮಳೆಯಲ್ಲಿ ಆಫೀಸ್ ಹೋಗುವವರೇ, ಈ 'ನೋ-ಕುಕ್' ಪ್ರೋಟೀನ್ ಮೀಲ್ಸ್ ಮಿಸ್ ಮಾಡ್ಬೇಡಿ!
ಏನಿದು ಯೂರಿನ್ ಕಲ್ಚರ್ ಟೆಸ್ಟ್? ಇದರ ಬಗ್ಗೆ ವೈದ್ಯರು ಏನು ಹೇಳುತ್ತಾರೆ?
ಮೂತ್ರದ ಕಲ್ಚರ್ ಪರೀಕ್ಷೆ (ಯೂರಿನ್ ಕಲ್ಚರ್ ಟೆಸ್ಟ್)ಎಂದರೆ, ನಿಮ್ಮ ಮೂತ್ರದಲ್ಲಿರುವ ಬ್ಯಾಕ್ಟೀರಿಯಾಗಳನ್ನು ಗುರುತಿಸಲು ಸಹಕರಿಸುವ ಒಂದು ವೈದ್ಯಕೀಯ ಪರೀಕ್ಷೆ ಆಗಿದೆ..ಈ ಪರೀಕ್ಷೆಯ ಸಹಾಯದಿಂದ ನೀವು ನಿಮ್ಮ ಮೂತ್ರನಾಳದ ಸೋಂಕಿಗೆ (UTI). ಕಾರಣವಾಗುವ ಸೂಕ್ಷ್ಮ ಜೀವಿಗಳನ್ನು ಪತ್ತೆ ಮಾಡಿ ಗುರುತಿಸಬಹುದು. ಮೂತ್ರ ವಿಸರ್ಜನೆಯ ಸಂದರ್ಭದಲ್ಲಿ ಬ್ಯಾಕ್ಟೀರಿಯಾಗಳು ಮೂತ್ರನಾಳದ ಒಳಗೆ ಪ್ರವೇಶಿಸಿ ಮೂತ್ರನಾಳದ ಸೋಂಕಿಗೆ ಪ್ರಮುಖವಾಗಿ ಕಾರಣವಾಗುತ್ತದೆ. ನಿಮ್ಮ ಮೂತ್ರದ ಪರಿಸರದಲ್ಲಿ, ಈ ಬ್ಯಾಕ್ಟೀರಿಯಾಗಳು ಬಹಳ ಬೇಗನೆ ಬೆಳವಣಿಗೆ ಹೊಂದುತ್ತದೆ ಮತ್ತು ಅದು ಕೆಲವು ವಿದಧ ಭಯಾನಕ ಸೋಂಕುಗಳಿಗೂ ಕಾರಣವಾಗಿ ಬಿಡುತ್ತದೆ.
ಮೂತ್ರನಾಳದ ಸೋಂಕಿನ ಕೆಲವು ಚಿಹ್ನೆಗಳಿದ್ದು, ಅದನ್ನು ಪ್ರತಿಯೊಬ್ಬರೂ ಗುರುತಿಸಿಕೊಳ್ಳಬಹುದಾಗಿದೆ. ಈ ಚಿಹ್ನೆಗಳು ಒಂದೇ ನೋವು ಕೂಡ ಆಗಿರಬಹುದು ಅಥವಾ ಕೆಳ ಹಿಂಭಾಗದಲ್ಲಿ ಆರಾಮಿಲ್ಲದ ಅನುಭವವೂ ಆಗಿರಬಹುದು ಅಥವಾ ಕಿಬ್ಬೊಟ್ಟೆಯ ಪ್ರದೇಶದಲ್ಲೂ ನೋವಿರಬಹುದು, ಜ್ವರ , ಯಾವಾಗಲೂ ಮೂತ್ರ ವಿಸರ್ಜನೆಗೆ ಹೋಗುತ್ತಲೇ ಇರಬೇಕು ಎಂದು ಅನ್ನಿಸುತ್ತಿರಬಹುದು, ಇತ್ಯಾದಿ ಯಾವುದೇ ಚಿಹ್ನೆಗಳೂ ಕೂಡ ಆಗಿರಬಹುದು. ಒಂದು ವೇಳೆ ಈ ರೀತಿಯ ಯಾವುದೇ ಮೂತ್ಪನಾಳದ ಸಮಸ್ಯೆ ಇದ್ದಲ್ಲಿ, ನಿಮ್ಮ ಮೂತ್ರದ ಬಣ್ಣದಲ್ಲಿ ಬದಲಾವಣೆ ಆಗಬಹುದು, ಪಿಂಕ್ ಬಣ್ಣ ಅಥವಾ ರಕ್ತವೂ ಹೋಗುತ್ತಿದ್ದರೆ ಸ್ವಲ್ಪ ರೆಡ್ಡಿಷ್ ಆಗಿ ಕೂಡ ಇರಬಹುದು ಅಥವಾ ಅತಿಯಾಗಿ ಹಳದಿ ಬಣ್ಣಕ್ಕೆ ತಿರುಗಿರಬಹುದು.
ನೀವು ಪದೇ ಪದೇ ಮೂತ್ರ ವಿಸರ್ಜನೆಗೆ ತೆರಳಬೇಕು ಎಂಬ ಭಾವನೆ ಹೊಂದಿ, ಪದೇ ಪದೇ ತೆರಳುತ್ತಿದ್ದರೂ ಕೂಡ, ನಿಮಗೆ ನಿಮ್ಮ ಮೂತ್ರಕೋಶದಲ್ಲಿ ಸ್ವಲ್ಪವೇ ಸ್ವಲ್ಪ ಮೂತ್ರವನ್ನು ಇಟ್ಟುಕೊಳ್ಳುವುದಕ್ಕೂ ಆಗದೇ ಇರುವ ಪರಿಸ್ಥಿತಿ ಎದುರಾಗಿರಬಹುದು. ಇಂತಹ ಸಂದರ್ಬದಲ್ಲಿ ಸೋಂಕು ಗಂಭೀರ ಸ್ಥಿತಿಗೆ ತಲುಪಿದೆ ಎಂದರ್ಥ ಮತ್ತು ನೀವು ಅಲುಗಾಡುತ್ತಿರುವಂತಹ ಅಥವಾ ಶೀತ ಅಥವಾ ವಾಂತಿ , ವಾಕರಿಕೆ ಬರುವಂತಹ ಅನುಭವವನ್ನು ಎದುರಿಸುತ್ತಿರಬಹುದು. ಮೂತ್ರ ಸಂಸ್ಕೃತಿ ಪರೀಕ್ಷೆಯಲ್ಲಿ. ಮೂತ್ರವನ್ನು ಸಂಗ್ರಹಿಸಲಾಗುತ್ತೆ ಮತ್ತು ಮುಂದಿನ ಹಂತದ ಪರೀಕ್ಷೆಗಳನ್ನು ಮಾಡಲಾಗುತ್ತೆ. ಮೂತ್ರ ಪರೀಕ್ಷೆಗಾಗಿ ಮೂತ್ರ ಸಂಗ್ರಹಣೆಯನ್ನು ವಿವಿಧ ರೀತಿಯಲ್ಲಿ ಮಾಡಬಹುದು. ಕೆಲವೊಂದು ವಿಧಾನಗಳನ್ನು ಇಲ್ಲಿ ವಿವರಿಸಲಾಗಿದೆ ಮತ್ತು ಆ ಮೂಲಕ ನೀವು ಮೂತ್ರ ಸಂಸ್ಕೃತಿ ಪರೀಕ್ಷೆಯನ್ನು ಹೇಗೆ ಕೈಗೊಳ್ಳುತ್ತಾರೆ ಎಂಬ ಬಗ್ಗೆ ತಿಳಿದುಕೊಳ್ಳಲು ನೆರವಾಗಲಿದೆ.
1. ಶುದ್ಧ ಕ್ಯಾಚ್ ವಿಧಾನ
2. ಮೂತ್ರದ ಸಂಗ್ರಹ ಬ್ಯಾಗ್ ವಿಧಾನ
3. ಕ್ಯಾತಿಟರ್ ವಿಧಾನ
4. ಸುಪ್ರಾಪ್ಯೂಬಿಕ್ ಆಕಾಂಕ್ಷೆ ವಿಧಾನ
1. ಶುದ್ಧ ಕ್ಯಾಚ್ ವಿಧಾನ - ಮೂತ್ರದ ಮಾದರಿಯ ಸಂಗ್ರಹಣೆಗಾಗಿ ಬಳಸುವ ಒಂದು ವಿಧಾನಗಳಲ್ಲಿ ಕ್ಲೀನ್ ಕ್ಯಾಚ್ ವಿಧಾನವೂ ಒಂದು.. ಮೂತ್ರದ ಮಾದರಿ ಸಂಗ್ರಹಣೆಗಾಗಿ ಬಳಸುವ ಒಂದು ಸಾಮಾನ್ಯ ವಿಧಾನವೆಂದರೆ ಅದು ಮಧ್ಯಮ ಶುದ್ಧ ಕ್ಯಾಚ್ ವಿಧಾನ. ಈ ವಿಧಾನದಲ್ಲಿ, ನೀವು ನಿಮ್ಮ ಮೂತ್ರವನ್ನು ಒಂದು ಕಪ್ ನಲ್ಲಿ ಸಂಗ್ರಹಿಸುತ್ತೀರಿ ಮತ್ತು ಅದನ್ನು ನಿಮ್ಮ ಮೂತ್ರದ ಮಾದರಿ ಪರೀಕ್ಷೆಗಾಗಿ ಬಳಕೆ ಮಾಡಲಾಗುತ್ತೆ.
2. ಮೂತ್ರದ ಸಂಗ್ರಹ ಬ್ಯಾಗ್ ವಿಧಾನ - ಮೂತ್ರದ ಮಾದರಿ ಸಂಗ್ರಹಣೆಗಾಗಿ ವ್ಯಾಪಕವಾಗಿ ಬಳಕೆ ಮಾಡುವ ಮತ್ತೊಂದು ವಿಧಾನವೆಂದರೆ ಅದು ಮೂತ್ರದ ಸಂಗ್ರಹ ಬ್ಯಾಗ್ ವಿಧಾನ..ಈ ವಿಧಾನವನ್ನು ಮಕ್ಕಳಲ್ಲಿ ಮತ್ತು ಚಿಕ್ಕ ಮಗುವಿನ ಮೂತ್ರ ಪರೀಕ್ಷೆಗಾಗಿ ಹೆಚ್ಚು ಬಳಕೆ ಮಾಡಲಾಗುತ್ತದೆ.ಈ ವಿಧಾನದಲ್ಲಿ ಮಕ್ಕಳ ಜನನಾಂಗಕ್ಕೆ ಒಂದು ಅಂಟಿಕೊಳ್ಳುವಂತ ಬ್ಯಾಗನ್ನು ಅಂಟಿಸಲಾಗುತ್ತೆ ಮತ್ತು ಮಕ್ಕಳು ಮೂತ್ರ ವಿಸರ್ಜಿಸಿದಾಗ ಅದು ಅದರಲ್ಲಿ ಸಂಗ್ರಹವಾಗಲಿದೆ.
3. ಕ್ಯಾತಿಟರ್ ವಿಧಾನ - ಕ್ಯಾತಿಟರ್ ವಿಧಾನವೂ ಮೇಲೆ ತಿಳಿಸಿದ ಎರಡು ವಿಧಾನಗಳಿಗಿಂತ ಮೂತ್ರದ ಮಾದರಿಯನ್ನು ಜನರಿಂದ ಸಂಗ್ರಹಿಸಲು ಬಳಸುವ ಸ್ವಲ್ಪ ಕಠಿಣವಾದ ವಿಧಾನವಾಗಿದೆ.. ಕೆಲವೊಮ್ಮೆ ಆರೋಗ್ಯ ಮೇಲ್ವಿಚಾರಕರ ಸಹಾಯದಿಂದಾಗಿ ಮೂತ್ರದ ಮಾದರಿಯನ್ನು ಸಂಗ್ರಹಿಸಬೇಕಾಗುತ್ತದೆ.. ಇದನ್ನು ಮಾಡುವ ಉದ್ದೇಶದಿಂದಾಗಿ ಕ್ಯಾತಿಟರ್ ನ್ನು ವ್ಯಕ್ತಿಯ ಮೂತ್ರನಾಳದ ಒಳಗೆ ಸೇರಿಸಲಾಗಿರುತ್ತದೆ.ಆ ಮೂಲಕ ಆರೋಗ್ಯ ಮೇಲ್ವಿಚಾರಕರು ಮೂತ್ರದ ಮಾದರಿಯನ್ನು ಸಂಗ್ರಹಿಸುತ್ತಾರೆ.
4. ಸುಪ್ರಾಪ್ಯೂಬಿಕ್ ಆಕಾಂಕ್ಷೆ ವಿಧಾನ - ಊತ್ರದ ಮಾದರಿ ಸಂಗ್ರಹಣೆಗಾಗಿ ಮೇಲೆ ತಿಳಿಸಿದ ಉಳಿದ ಎಲ್ಲಾ ವಿಧಾನಗಳಿಗಿಂತ ಈ ಸುಪ್ರಾಫ್ಯೂಬಿಕ್ ಆಕಾಂಕ್ಷೆ ವಿಧಾನವನ್ನು ಬಹಳ ಕಡಿಮೆ ಬಳಕೆ ಮಾಡಲಾಗುತ್ತೆ.ಆದರೆ,ತುಂಬಾ ಅಪರೂಪದ ಸಂದರ್ಬಗಳಲ್ಲಿ, ವೈದ್ಯರು ಮೂತ್ರಕೋಶದಲ್ಲಿರುವ ಮೂತ್ರವನ್ನು ಸೂಜಿಯ ಮೂಲಕ ಹೊರ ತೆಗೆಯಬೇಕಾದ ಸಂದರ್ಬ ಬರಬಹುದು. ಈ ವಿಧಾನವನ್ನೇ ಸೂಪ್ರಾಫ್ಯೂಬಿಕ್ ಆಕಾಂಕ್ಷೆ ವಿಧಾನ ಎಂದು ಕರೆಯುತ್ತಾರೆ.
ಮೂತ್ರದ ಅಸಂಘಟಿತ ಮಾದರಿಯನ್ನು ಸಂಗ್ರಹಿಸುವ ಹಿಂದಿನ ಪ್ರಯತ್ನಗಳು ವಿಫಲವಾದರೆ ಇದನ್ನು ಬಳಸಲಾಗುತ್ತದೆ. ಈ ರೀತಿ ಮೂತ್ರವನ್ನು ಸಂಗ್ರಹಿಸಬೇಕಾಗಿರುವುದು ನೀವು ಒಂದು ವೇಳೆ ಮೂತ್ರಕೋಶದಲ್ಲಿ ನೋವು ಅನುಭವಿಸುತ್ತಿದ್ದು, ಮೂತ್ರವೇ ಮಾಡಲು ಸಾಧ್ಯವಾಗದ ಸಂದರ್ಬವಿದ್ದು, ಮೂತ್ರ ಪರೀಕ್ಷೆ ಮಾಡಿಸಲೇ ಬೇಕಾದ ಅನಿವಾರ್ಯತೆ ಇದ್ದಾಗ, ಇಲ್ಲದೇ ಇದ್ದರೆ ಇದು ಖಂಡಿತ ಯಾವುದೇ ನೋವು ನೀಡುವುದಿಲ್ಲ.ಮೂತ್ರ ಸಂಸ್ಕೃತಿ ಪರೀಕ್ಷೆಗಾಗಿ, ಮೂತ್ರವನ್ನು ಹಲವು ದಿನಗಳವರೆಗೆ ಹಾಗೆಯೇ ಇಡಲಾಗುತ್ತೆ ಮತ್ತು ಬ್ಯಾಕ್ಟೀರಿಯಾಗಳನ್ನು ಬೆಳೆಯುವಂತೆಯೂ ಮಾಡಲಾಗುತ್ತದೆ.
ನಂತರ, ಮೈಕ್ರೋಸ್ಕೋಪ್ ಬಳಸಿ ಅದನ್ನು ಪರೀಕ್ಷೆಗೆ ಒಳಪಡಿಸಲಾಗುತ್ತೆ. ಒಂದು ವೇಳೆ, ಕೇವಲ ಕೆಲವೇ ಕೆಲವು ಬ್ಯಾಕ್ಟೀರಿಯಾ ಅಥವಾ ಜೀವಕೋಶಗಳು ಪತ್ತೆಯಾದರೆ, ನಿಮ್ಮ ಪರೀಕ್ಷೆ ನೆಗೆಟಿವ್ ಆಗಿರಲಿದೆ, ಆದರೆ, ಒಂದು ವೇಳೆ ಹಲವಾರು ಬ್ಯಾಕ್ಟೀರಿಯಾ ಮತ್ತು ಜೀವಕೋಶಗಳು ಮೈಕ್ರೋಸ್ಕೋಪ್ ಮುಖಾಂತರ ಪತ್ತೆಯಾದರೆ, ಫಲಿತಾಂಶವನ್ನು ಧನಾತ್ಮಕ ಎಂದು ಪರಿಗಣಿಸಲಾಗುತ್ತೆ. ಯಾವ ವ್ಯಕ್ತಿ ಮೂತ್ರ ಸಂಸ್ಕೃತಿ ಪರೀಕ್ಷೆ ಕೈಗೊಳ್ಳುವ ವ್ಯಕ್ತಿ, ಯಾವ ಬ್ಯಾಕ್ಟೀರಿಯಾ ಮತ್ತು ಜೀವಕೋಶವು ನಿಮಗೆ ಸೋಂಕನ್ನು ತಂದಿದೆ ಎಂಬುದನ್ನೂ ಕಂಡುಹಿಡಿಯಲು ಸಾಧ್ಯವಿದೆ.
ಇದು ದೃಷ್ಟಿಗೋಚರದಿಂದ ಅಥವಾ ಇನ್ನೂ ಹೆಚ್ಚಿನ ಪರೀಕ್ಷೆಯ ಮೂಲಕ ನಡೆಸಲು ಸಾಧ್ಯವಾಗುತ್ತದೆ. ಮೂತ್ರ ಸಂಸ್ಕೃತಿ ಪರೀಕ್ಷೆಯ ಫಲಿತಾಂಶವು 2 -3 ದಿನದಲ್ಲಿ ಗೊತ್ತಾಗಿ ಬಿಡುತ್ತದೆ. ಒಂದು ವೇಳೆ ನಿಮ್ಮ ಮೂತ್ರ ಕಲ್ಚರ್ ಪರೀಕ್ಷೆ ಫಲಿತಾಂಶವು ಧನಾತ್ಮಕವಾಗಿ ಬಂದರೆ, ವೈದ್ಯರು ನಿಮಗೆ ಆಂಟಿ ಬಯೋಟಿಕ್ ಮತ್ತು ಸೋಂಕು ನಿವಾರಿಸುವ ಮಾತ್ರೆಗಳನ್ನು ಪರಿಹಾರವಾಗಿ ಸೂಚಿಸಲಿದ್ದಾರೆ. ಇದು ಯೂರಿನ್ ಕಲ್ಚರ್ ಟೆಸ್ಟ್ ಸಾಮಾನ್ಯವಾಗಿ ಹೇಗೆ ನಡೆಯುತ್ತದೆ ಮತ್ತು ಅದರ ಕಾರ್ಯನಿರ್ವಹಣೆಯ ಸಾಮಾನ್ಯ ವಿವರಣೆಯಾಗಿದೆ..
Disclaimer: ಈ ಲೇಖನದಲ್ಲಿ ಒದಗಿಸಲಾದ ಮಾಹಿತಿಯು ಸಾಮಾನ್ಯ ಮಾಹಿತಿ ಮತ್ತು ಶೈಕ್ಷಣಿಕ ಉದ್ದೇಶಗಳಿಗಾಗಿ ಮಾತ್ರವಾಗಿದೆ. ವೃತ್ತಿಪರ ವೈದ್ಯಕೀಯ ಸಲಹೆ, ರೋಗನಿರ್ಣಯ ಅಥವಾ ಚಿಕಿತ್ಸೆಗೆ ಪರ್ಯಾಯವಾಗಿ ಇದನ್ನು ದೃಢೀಕರಿಸಿಲ್ಲ. ವೈದ್ಯಕೀಯ ಸ್ಥಿತಿಯ ಕುರಿತು ನೀವು ಹೊಂದಿರುವ ಯಾವುದೇ ಪ್ರಶ್ನೆಗಳಿಗೆ ಯಾವಾಗಲೂ ನಿಮ್ಮ ವೈದ್ಯರು ಅಥವಾ ಅರ್ಹ ಆರೋಗ್ಯ ಸಿಬ್ಬಂದಿಯ ಸಲಹೆಯನ್ನು ಪಡೆಯಿರಿ.



Click it and Unblock the Notifications